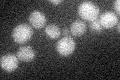
YFL060C
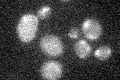
YFL060C

View description
Protein of unknown function, nearly identical to Sno2p; expression is induced before the diauxic shift and also in the absence of thiamin
Localization:
Intensity:
Fold change:
Significance:
-
C’ GFP library in SD
below threshold18.02 -
N' NOP1pr-GFP in SD

cytosol73.057 -
N' TEF2pr-mCherry in SD

cell periphery,vacuoleN/A -
N' NATIVEpr-GFP in SD

missing0 -
N' TEF2pr-VC and Cyto-VN in SD

#N/A0 -
C’ GFP library in SD+DTT

cytosol20.971.16No -
C’ GFP library in SD+H2O2
cytosol16.030.88No -
C’ GFP library in Starvation Media

cytosol17.360.96No -
C’ GFP library on the background of Pup2-DaMP

below threshold -
C’ GFP library on the background of CCT mutant

below threshold17.70130.981737No
